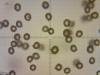
1414092015_1_t1.jpg
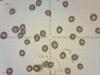
1514092015_1_t1.jpg
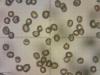
lactarius_t1.jpg

|
|
322

Russula008
Дата: 26.09.15
Добавлено: arfey
Комментариев: 0
Просмотров: 1051
|
323

Russula005
Дата: 26.09.15
Добавлено: arfey
Комментариев: 0
Просмотров: 989
|
|
|
|
|
|
|
329

Russula009
Дата: 27.09.15
Добавлено: arfey
Комментариев: 0
Просмотров: 1024
|
330

Agaricus002
Дата: 27.09.15
Добавлено: arfey
Комментариев: 0
Просмотров: 1020
|
|
|
|
|
|
|
336

Noname006
Дата: 14.11.15
Добавлено: arfey
Комментариев: 0
Просмотров: 1013
|
|
|
|
|
341

Agaricus005
Дата: 14.11.15
Добавлено: arfey
Комментариев: 0
Просмотров: 1082
|
|
343

Noname008
Дата: 14.11.15
Добавлено: arfey
Комментариев: 0
Просмотров: 1101
|
|
|
|
|
|
|
|
|
|
|
|
|
|
|
356

Noname007
Дата: 14.11.15
Добавлено: arfey
Комментариев: 0
Просмотров: 1027
|
|
|
|
|
















































 грибы
грибы фотогалерея
фотогалерея флора
флора фауна
фауна птицы
птицы млекопитающие
млекопитающие пресмыкающиеся
пресмыкающиеся земноводные
земноводные бабочки
бабочки насекомые
насекомые рыбы
рыбы видео
видео казахстан
казахстан кулинария
кулинария статьи
статьи ссылки
ссылки о нас
о нас